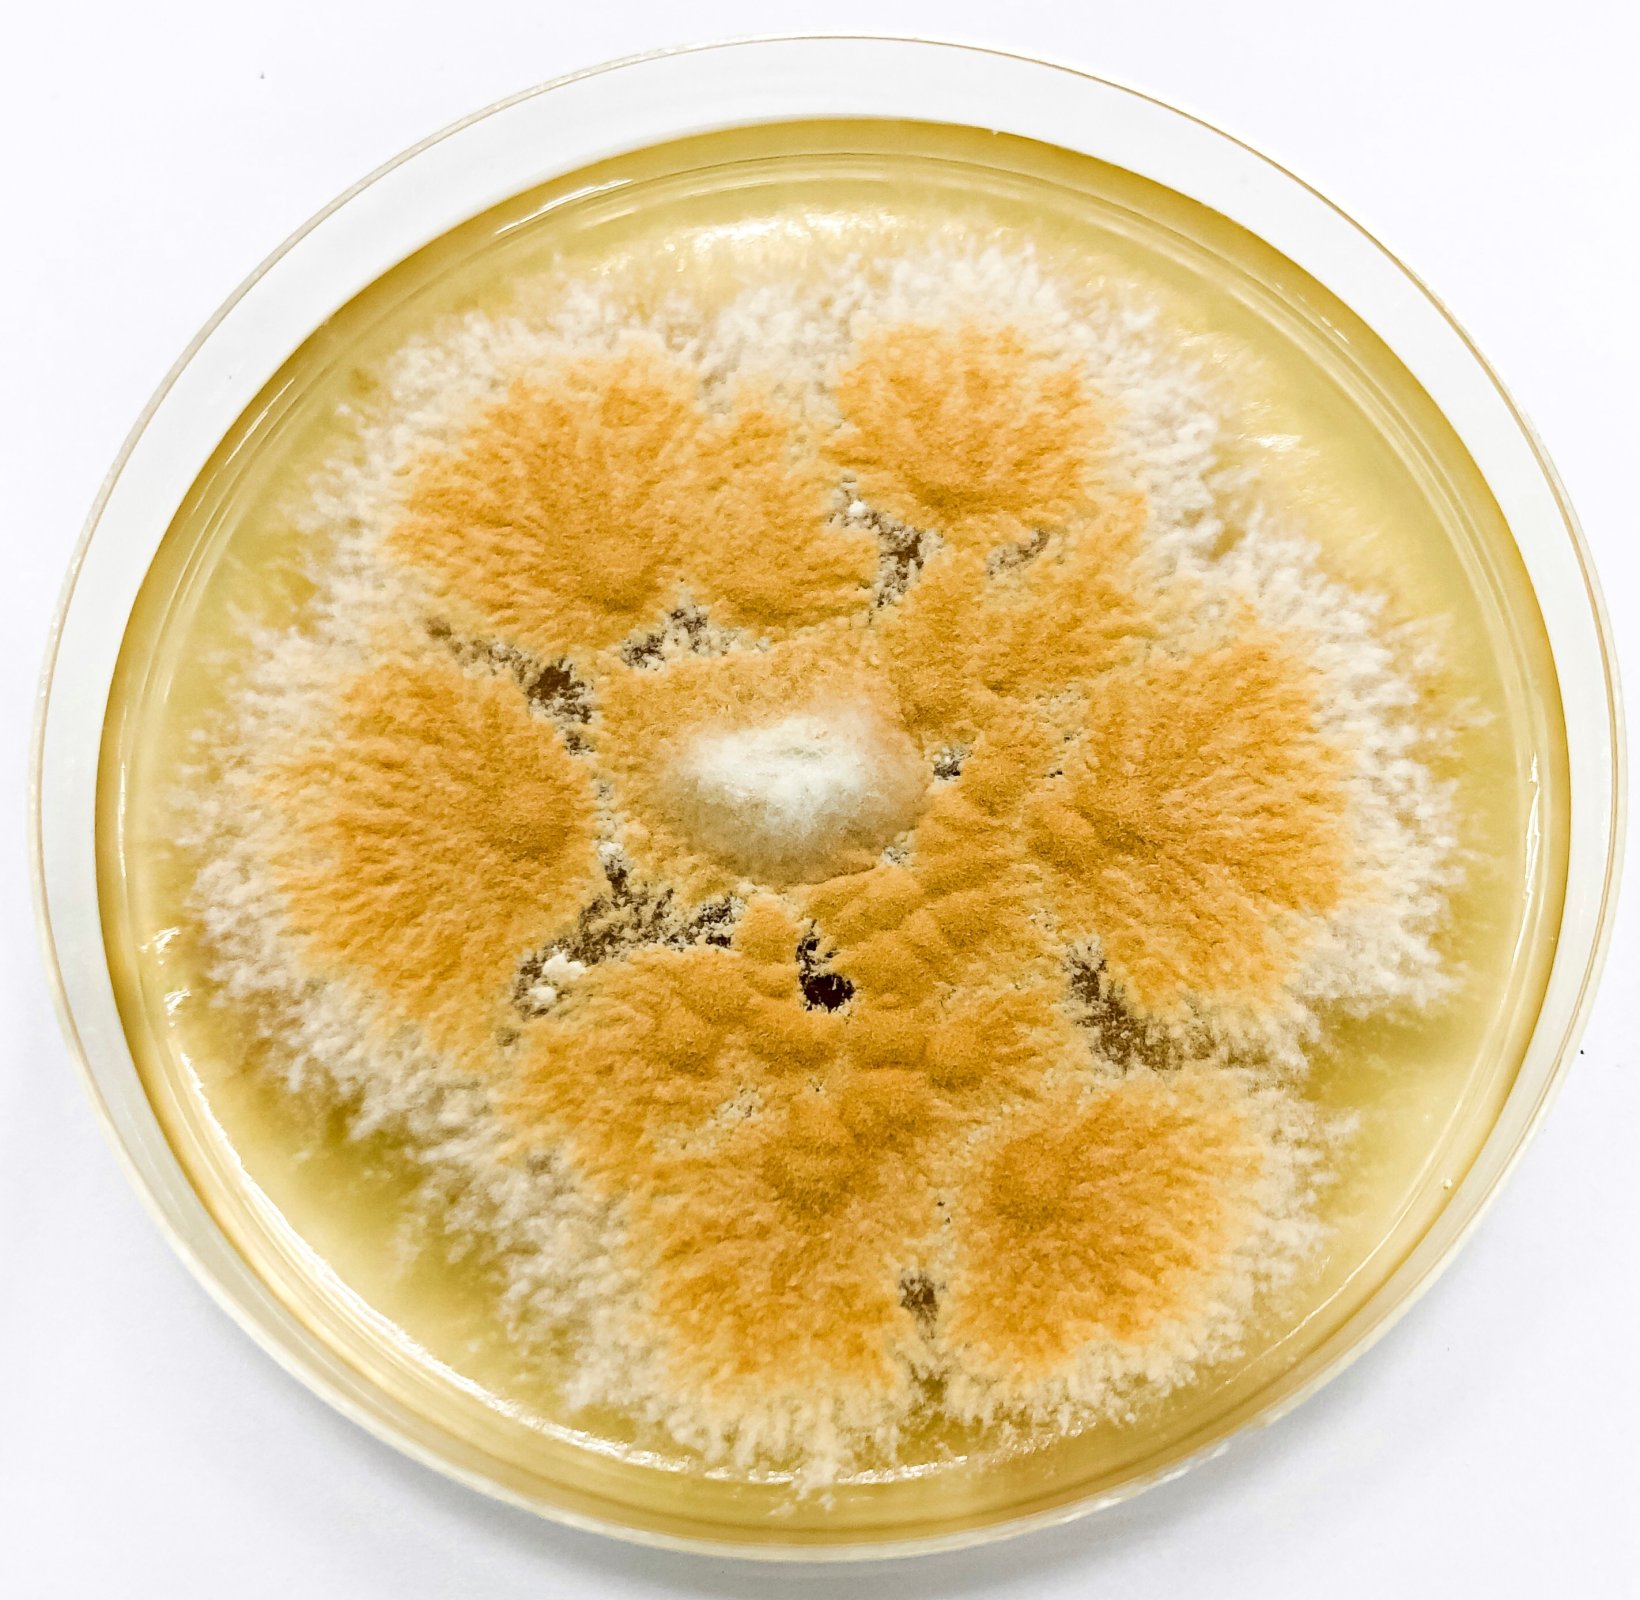

Microsporum
Botanika / Mykologie
[Mikrosporum], Microsporon, rod plísní imperfektního stadia z čeledi Gymnoascaceae. Působí dermatomykózy. Známo 14 druhů. Pro člověka je patogenní Microsporum audouini, parazitující na vlasech; Microsporum canis bylo izolováno u zvířat a lidí a Microsporum gypseum se nachází hlavně v půdě.
Vytvořeno:
14. 3. 2000
Aktualizováno:
17. 7. 2008
Autor: -red-
Odkazující hesla: dermatomykózy.
Vyzkoušejte si s přáteli Kvízy encyklopedie CoJeCo.cz!